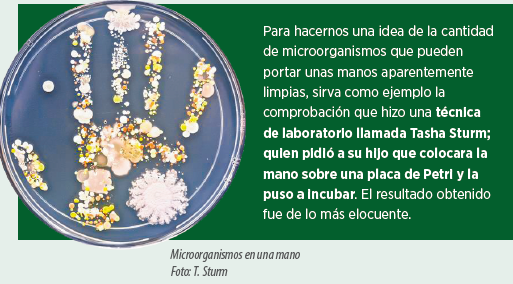

Bioseguridad interna y del personal

Estamos en el siglo XXI. Hoy en día, a todo el personal sanitario se le recomienda y explica cómo mantener la higiene de sus manos para evitar convertirse ellos mismos en vectores de infinidad de patógenos.
Por parte de las autoridades sanitarias se insiste también a la población sobre la importancia de lavarse las manos ante brotes de gripe, prevenir contagios, contener el avance de las resistencias a los antibióticos, etc.
Incluso se ha establecido el 15 de octubre como el “Día mundial del lavado de manos”.
La importancia de lavarse las manos es también extrapolable a la producción agropecuaria actual, donde cada detalle cuenta a la hora de alcanzar los exigentes objetivos de producción, reducción de medicaciones —especialmente antibióticos— estándares de bienestar animal y seguridad alimentaria sin importar el tipo de ganadería, ya sean maternidades o engordes de porcino, plantas de incubación, cría o puesta en avicultura, modernas granjas de producción lechera, etc.
En este contexto, la bioseguridad interna se entiende como todos aquellos procesos que van encaminados a reducir el riesgo de difusión de patógenos dentro de las explotaciones, ya sean acciones de higiene sobre el propio personal o los animales, manejo, profilaxis vacunal o combinaciones de todas ellas.
Se refiere a todas las medidas que adoptamos mientras estamos tratando con los animales, no solo en los vacíos sanitarios de las naves o las salas.
La higiene del personal abarcará todas las medidas aplicadas una vez pasada la etapa de la ducha preceptiva antes de ingresar a la explotación.

De la misma manera, la desinfección de las manos, más allá del simple lavado, sería recomendable para evitar el contagio entre camadas, entre diferentes salas, lotes, etc.
No podemos olvidar el ejemplo anterior de la gripe, así como patologías más concretas de cada especie animal, como el virus del PRRS que puede ser vehiculado a través de nuestras manos de unos animales a otros.
Hemos de considerar que las duchas, así como el concienzudo lavado frecuente de manos —en ocasiones con agentes antisépticos— pueden protegernos a nosotros mismos de la infección por agentes como Staphilococcus aureus resistente a meticilina (SARM), a tetraciclina (SART) o multirresistente, el cual supone un riesgo real de infección para el personal que trabaja con animales, riesgo que se eleva hasta seis veces más en el caso del personal en contacto con ganado porcino, según un estudio publicado en 2015 y llevado a cabo por investigadores de las universidades de Iowa, Kent y el National Cancer Institute de Estados Unidos.
Idéntico celo higiénico se ha de poner en la vestimenta, ropa y útiles de trabajo. La desinfección de los materiales con que manejamos a los animales debería ser rutinaria entre diferentes lotes de los mismos para evitar esas contaminaciones cruzadas. Lo mismo ocurre con la ropa, ya sean monos de trabajo, toallas, trapos, etc., para los que a veces puede no ser suficiente el simple lavado habitual con detergente, al cual pueden resistir determinados patógenos que sobreviven a los ciclos de lavado e incluso pueden permanecer acantonados contaminando la lavadora, que se convertirá a su vez en un reservorio de los mismos, tal como
asegura Kelly Reynolds, investigadora de la Universidad de Arizona.
Sería necesario someter la ropa a tratamientos periódicos de desinfección mediante desinfectantes formulados a tal fin para asegurarnos de que el propio mono de trabajo no se convierte en un fómite de transmisión que perpetúe patologías entre diferentes lotes de animales.
Envejecimiento de la solución desinfectante.
Escaso o nulo tiempo de contacto que se aplica.
La solución desinfectante a de reponerse a diario o cada dos o tres días como máximo, dependiendo del nivel de uso pues, una vez contaminada con materia orgánica, se inactivará y solo servirá como caldo de cultivo para los patógenos, consiguiendo un efecto totalmente contrario al pretendido.
A la hora de emplear los pediluvios para la limpieza del calzado hemos de concederle un mínimo de tiempo de contacto al desinfectante, parándonos completamente durante unos cuantos segundos en el pediluvio para que pueda cubrir suficientemente la bota y de esta manera empapar bien toda la suela.

Otro capítulo importante dentro de la bioseguridad interna, además de la propia higiene del personal, es la higiene de los animales. Es muy útil, a modo preventivo, la práctica establecida en granjas de ganado porcino de lavar las cerdas antes de entrar a partos con desinfección de la zona vulvar y mamas un día o dos antes del parto; práctica cada vez más extendida por hacerse evidentes sus efectos positivos sobre la sanidad de la
camada en los primeros momentos de vida —que son críticos— además de ayudar a prevenir la aparición de patologías como la epidermitis exudativa.
Es importante prestar especial atención a los circuitos de alimentación en los lugares donde se emplea alimentación líquida o soluciones de leche maternizada como apoyo a los lechones lactantes. Igual que se empieza a dar importancia a las tuberías de conducción de agua en los vacíos sanitarios, los circuitos de alimentación en líquido han de ser tenidos en cuenta como parte inexcusable de la higiene durante la producción.
Los circuitos de alimentación en líquido deben limpiarse con frecuencia tras su utilización empleando un detergente para circuitos, formulado para este uso y que retire los restos de materia orgánica adheridos a la superficie. Lo ideal sería limpiar los circuitos cada vez que se emplean, o en veces alternas, y someterlos a un tratamiento semanal de desinfección con un desinfectante con autorización de uso en industria alimentaria, pues así se consideran este tipo de circuitos desde el punto de vista de la legislación de biocidas, al estar en contacto con alimentos.
En este aspecto, existe la creencia más o menos extendida de que dichos circuitos no deben limpiarse con excesiva frecuencia porque así se genera en ellos una flora láctica beneficiosa para los animales.
Esto no es exacto, es como si le propusiésemos a una industria láctea que no limpiase sus circuitos después de elaborar cada partida de yogur, por ejemplo.
Los circuitos de alimentación deben ser mantenidos y limpiados a menudo, así como desinfectados con asiduidad, pues dadas las condiciones en el interior de su luz y la actividad de agua de este tipo de alimentación, pueden convertirse en una plataforma perfecta para desarrollo de biofilms y proliferación de bacterias anaerobias o mohos, por ejemplo. Más aun en un clima cálido como el nuestro, donde, si a un
mantenimiento e higiene deficientes se le suman las altas temperaturas, el resultado puede ser que en verano la tubería “acabe cobrando vida propia”.
Es conveniente ahondar en la idea que siempre se pretende transmitir en torno a la bioseguridad, ya sea la externa o la interna como en este caso, de que ha de ser una práctica que se interiorice, se asuma y se implante como una filosofía continua de trabajo, formando al personal sobre sus bases y explicando que cada paso y cada detalle cuentan.
Más en un contexto como el que nos encontramos, en el que las exigencias productivas, sanitarias e incluso de imagen del sector agroganadero de cara a la sociedad y opinión pública son cada vez mayores.
Rafael Arlegui
Jefe de producto ganadería
Contacto:
Contacta con nosotros a través del siguiente formulario.
